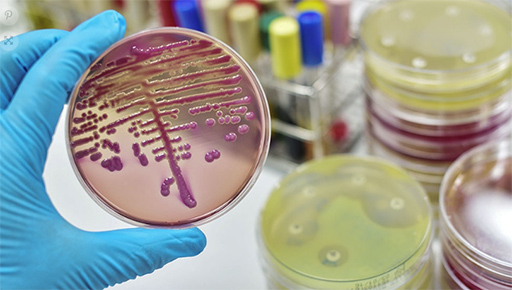

Contienen brote de una bacteria resistente a todas las drogas en Argentina
El Servicio Antimicrobianos del Instituto Nacional de Enfermedades Infecciosas (INEI)-Anlis Malbrán informó a la comunidad médica y científica que fue detectado y controlado un brote Klebsiella pneumoniae, sin casos fatales.
Leer más